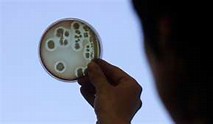

BRAVE NEW WORLD: Hackers “Take Control & Crash” Jeep Cherokee From A Sofa 10 Miles Away
Source – telegraph.co.uk – In what is being called “the first of its kind,” Wired.com reports that hackers, using just a laptop and mobile phone, accessed a Jeep Cherokee’s on-board systems (via its wireless internet connection), took control and crashed the car into a ditch from 10 miles away sitting on their sofa. As The…